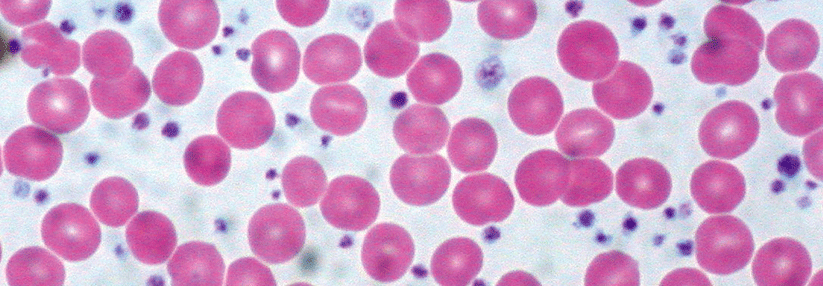

Beta-Thalassämie: Komplikationen durch therapiebedingte Eisenüberladung vermeiden
 Die Knochenmarkshyperplasie (hier im Schädel und Femur) führt zu Schmerzen und Deformitäten.
© Science Photo Library/Biophoto Associates
Die Knochenmarkshyperplasie (hier im Schädel und Femur) führt zu Schmerzen und Deformitäten.
© Science Photo Library/Biophoto Associates
Die Beta-Thalassämie ist eine autosomal-rezessiv vererbte Synthesestörung der Betaketten des Hämoglobins. Bisher sind mehr als 350 Mutationen beschrieben, die die Erkrankung auslösen können. Die Genveränderung verleiht Merkmalsträgern einen gewissen Schutz vor Malaria, weshalb sie vermehrt in Endemiegebieten von Subsahara-Afrika über den Mittelmeerraum und den Nahen Osten bis nach Südostasien zu finden ist, schreiben Dr. Ali Taher von der Amerikanischen Universität Beirut und Kollegen.
Therapiebedarf teilt Patienten in zwei Gruppen
Heterozygote Patienten haben üblicherweise allenfalls eine grenzwertig symptomatische Anämie mit Mikrozytose und Hypochromie. Homozygote Merkmalsträger…
Bitte geben Sie Ihren Benutzernamen und Ihr Passwort ein, um sich an der Website anzumelden.